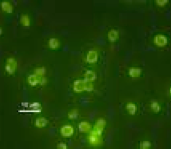

Soller Environmental, LLC is a small, client-focused consulting firm. Our focus is on regulatory decision making at the interface of science and environmental policy. We advise local, state, and federal decision makers and provide technical assistance for environmental policy development related to human health effects associated with waterborne contaminants and water-related media.
Founded in 2005, Soller Environmental, LLC supports a wide range of clients on the design, implementation, management and documentation of investigations related to water quality evaluation, health effects associated with exposure to water-borne contaminants, microbial risk assessment, water and wastewater treatment process performance evaluation, and statistical analysis of environmental data.